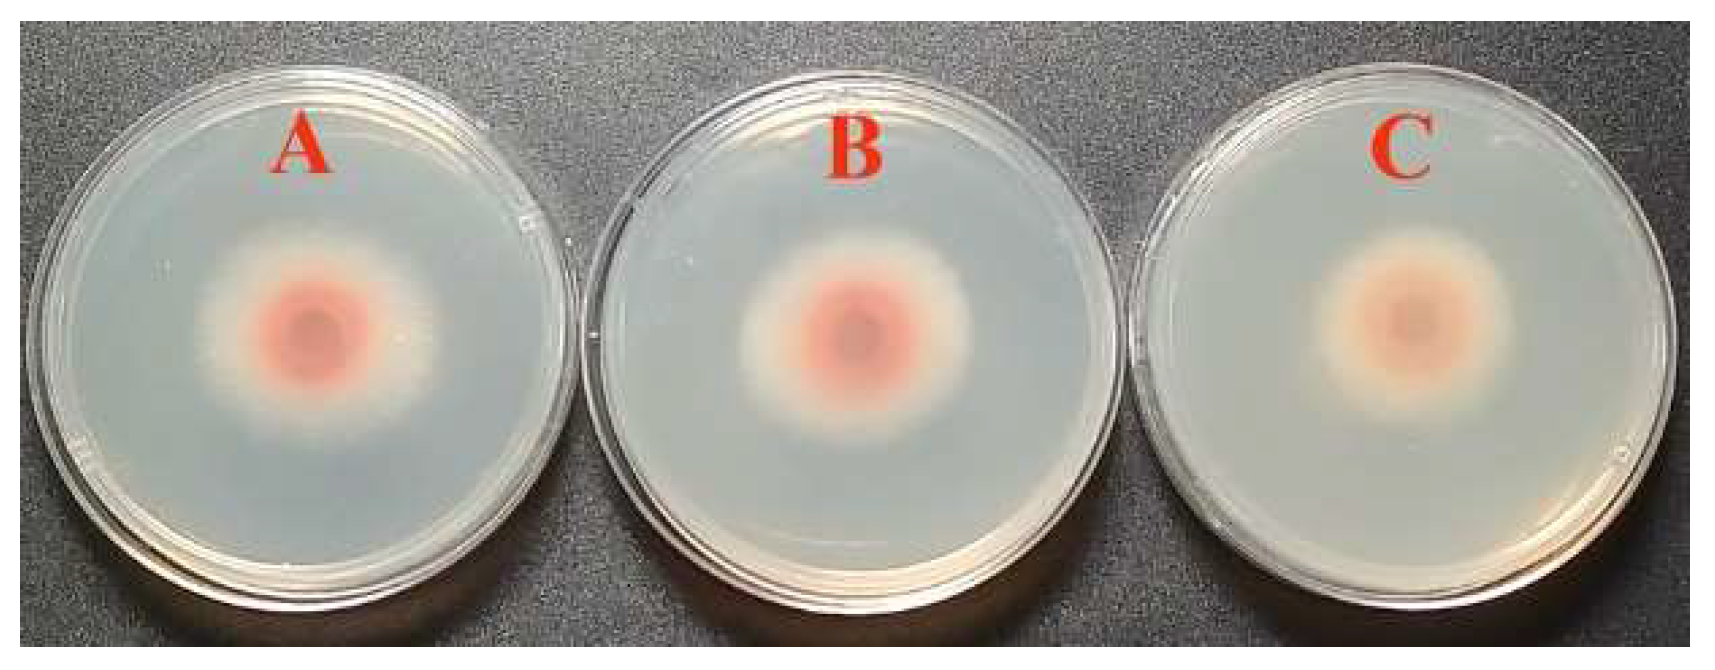
Horticulturae 09 01340 g001

Crude Saponins from Chenopodium quinoa Willd. Reduce Fusarium Wilt Infection in Tomato Seedlings
Abstract
:1. Introduction
2. Materials and Methods
2.1. Extraction of Saponins from Quinoa Bran
2.2. Proximate Analysis of Crude Saponins from Quinoa
2.3. Effects of Soaking Seeds with Saponin Solutions on Tomato Seedling Emergence
2.4. FOL Strains and Growth Conditions
2.5. Preparation of FOL Soil Inoculants
2.6. Effect of Quinoa Saponins on the Linear Mycelial Growth of FOL In Vitro
2.7. In Vivo Antifungal Activity of Seedlings after Seed Treatment
2.8. In Vivo Antifungal Activity of Seedlings after Root Soaking Treatment
2.9. In Vivo Antifungal Activity of Seedlings after Foliar Spray Treatment
2.10. Statistical Analysis
3. Results
3.1. Proximate Composition of Crude Saponins from Quinoa
3.2. Effects of Seed Soaking with Saponins on Tomato Seedling Emergence
3.3. In Vitro Activity of Quinoa Saponins against FOL
3.4. In Vivo Activity of Quinoa Saponins against FOL
3.4.1. Effect of Seed Soaking with Saponins on Seedling Resistance to Fusarium Wilt
3.4.2. Effect of Root Soaking with Saponins on Seedling Resistance to Fusarium Wilt
3.4.3. Effect of Foliar Spray with Saponins on Seedling Resistance to Fusarium Wilt
4. Discussion
5. Conclusions
Author Contributions
Funding
Data Availability Statement
Conflicts of Interest
References
- Abo-Elyousr, K.A.M.; AliE, F.; Sallam, N.M.A. Alternative control of tomato wilt using the aqueous extract of Calotropis procera. Horticulturae 2022, 8, 197. [Google Scholar] [CrossRef]
- Fujikawa, I.; Takehara, Y.; Ota, M.; Imada, K.; Sasaki, K.; Kajihara, H.; Sakai, S.; Jogaiah, S.; Ito, S. Magnesium oxide induces immunity against Fusarium wilt by triggering the jasmonic acid signaling pathway in tomato. J. Biotechnol. 2021, 325, 100–108. [Google Scholar] [CrossRef] [PubMed]
- Righini, H.; Cetrullo, S.; Bissoli, I.; Zuffi, V.; Quintana, A.M.; Flamigni, F.; Francioso, O.; Roberti, R. Evaluating Ecklonia maxima water-soluble polysaccharides as a growth promoter of tomato seedlings and resistance inducer to Fusarium wilt. Sci. Hortic. 2023, 317, 112071. [Google Scholar] [CrossRef]
- Wang, Y.; Liang, Y.; Zhang, Z.; Tang, L.; Huang, C.; Yang, L.; Zuo, X. Cultivation measures to improve tomato yield and quality in low light environment. China Cucurbits Veg. 2023, 36, 59–65. [Google Scholar]
- Song, W.; Zhou, L.; Yang, C.; Cao, X.; Zhang, L.; Liu, X. Tomato Fusarium wilt and its chemical control strategies in a hydroponic system. Crop. Prot. 2004, 23, 243–247. [Google Scholar] [CrossRef]
- Srinivas, C.; Devi, D.N.; Murthy, K.N.; Mohan, C.D.; Lakshmeesha, T.R.; Singh, B.; Kalagatur, N.K.; Niranjana, S.R.; Hashem, A.; Alqarawi, A.A.; et al. Fusarium oxysporum f. sp. lycopersici causal agent of vascular wilt disease of tomato: Biology to diversity–A review. Saudi J. Biol. Sci. 2019, 26, 1315–1324. [Google Scholar] [CrossRef] [PubMed]
- Khalil, M.M.R.; Fierro-Coronado, R.A.; Peñuelas-Rubio, O.; Villa-Lerma, A.G.; Plascencia-Jatomea, R.; Félix-Gastélum, R.; Maldonado-Mendoza, I.E. Rhizospheric bacteria as potential biocontrol agents against Fusarium wilt and crown and root rot diseases in tomato. Saudi J. Biol. Sci. 2021, 28, 7460–7471. [Google Scholar] [CrossRef]
- McGovern, R.J. Management of tomato diseases caused by Fusarium oxysporum. Crop. Prot. 2015, 73, 78–92. [Google Scholar] [CrossRef]
- Lu, C.; Ouyang, S. Research progress on molecular mechanism of tomato resistance to Fusarium Wilt. Vegetables 2021, 41, 37–42. [Google Scholar]
- The Institute of Plant Protection of Chinese Academy of Agricultural Sciences; Chinese Plant Protection Society. Crop Pests and Diseases in China, 3rd ed.; Agricultural Press of China: Beijing, China, 2015; Volume 2, pp. 60–64. [Google Scholar]
- Sefloo, N.G.; Steinkellner, S.; Hage-Ahmed, K. The bioprotective effect of root endophytic Serendipita herbamans against Fusarium wilt in tomato and its impact on root traits are determined by temperature. Rhizosphere 2021, 20, 100453. [Google Scholar] [CrossRef]
- Abdallah, R.A.B.; Stedel, C.; Garagounis, C.; Nefzi, A.; Jabnoun-Khiareddine, H.; Papadopoulou, K.K.; Daami-Remadi, M. Involvement of lipopeptide antibiotics and chitinase genes and induction of host defense in suppression of Fusarium wilt by endophytic Bacillus spp. in tomato. Crop Prot. 2017, 99, 45–58. [Google Scholar] [CrossRef]
- Ying-Tzu, L.; San-Gwang, H.; Yuh-Ming, H.; Cheng-Hua, H. Effects of Trichoderma asperellum on nutrient uptake and Fusarium wilt of tomato. Crop Prot. 2018, 110, 275–282. [Google Scholar]
- Coratoa, U.D.; Patruno, L.; Avella, N.; Salimbeni, R.; Lacolla, G.; Cucci, G.; Crecchio, C. Soil management under tomato-wheat rotation increases the suppressive response against Fusarium wilt and tomato shoot growth by changing the microbial composition and chemical parameters. Appl. Soil. Ecol. 2020, 154, 103601. [Google Scholar] [CrossRef]
- Elanchezhiyan, K.; Keerthana, U.; Nagendran, K.; Prabhukarthikeyan, S.R.; Prabakar, K.; Raguchander, T.; Karthikeyan, G. Multifaceted benefits of Bacillus amyloliquefaciens strain FBZ24 in the management of wilt disease in tomato caused by Fusarium oxysporum f. sp. Lycopersici. Physiol. Mol. Plant. Pathol. 2018, 103, 92–101. [Google Scholar] [CrossRef]
- Corato, U.D.; Cancellara, F.A.; Lacolla, G.; Caranfa, D.; Cucci, G. Short-term soil amendment by sewage sludge anaerobic digestate in a tomato monoculture suppresses Fusarium vascular wilt disease by changing the taxonomic characteristics of soil microbiota. Appl. Soil. Ecol. 2023, 189, 104915. [Google Scholar] [CrossRef]
- Ji, W. Screening and Metabolites of Antagonistic Actinomycetes against Fusarium oxysporum f. sp. Lycopersici. Master’s Thesis, Yangzhou University, Yangzhou, China, 2020. [Google Scholar]
- Abdelraouf, A.M.N.; Hussain, A.A.; Naguib, D.M. Nano-chitosan encapsulated Pseudomonas fluorescens greatly reduces Fusarium wilt infection in tomato. Rhizosphere 2023, 25, 100676. [Google Scholar] [CrossRef]
- Dong, Z.; Zhegn, A.; Wan, H. Effect of applying soil activation and remediation fungicide in high temperature and stuffy shed on continuous cropping obstacles of protected tomato. China Cucurbits Veg. 2021, 34, 70–73. [Google Scholar]
- Xu, Y.; Li, Y.; Xu, X. Progress in research on Fusarium wilt of tomato. J. Northeast Agric. Univ. 2008, 39, 128–134. [Google Scholar]
- Srivastava, R.; Khalid, A.; Singh, U.S.; Sharma, A.K. Evaluation of arbuscular mycorrhizal fungus, fluorescent Pseudomonas and Trichoderma harzianum formulation against Fusarium oxysporum f. sp. Lycopersici for the management of tomato wilt. Biol. Control. 2010, 53, 24–31. [Google Scholar] [CrossRef]
- Lopez-Lima, D.; Mtz-Enriquez, A.I.; Carrión, G. The bifunctional role of copper nanoparticles in tomato: Effective treatment for Fusarium wilt and plant growth promoter. Sci. Hortic. 2021, 277, 109810. [Google Scholar] [CrossRef]
- Zia, M.A.; Riaz, R.; Batool, A.; Yasmin, H.; Nosheen, A.; Naz, R.; Hassan, M.N. Glucanolytic rhizobacteria associated with wheat- maize cropping system suppress the Fusarium wilt of tomato (Lycopersicum esculentum L.). Sci. Hortic. 2021, 287, 110275. [Google Scholar] [CrossRef]
- Jayamohan, N.S.; Patil, S.V.; Kumudini, B.S. Seed priming with Pseudomonas putida isolated from rhizosphere triggers innate resistance against Fusarium wilt in tomato through pathogenesis-related protein activation and phenylpropanoid pathway. Pedosphere 2020, 30, 651–660. [Google Scholar] [CrossRef]
- Sriwati, R.; Maulidia, V.; Intan, N.; Oktarina, H.; Khairan, K.; Skala, L.; Mahmud, T. Endophytic bacteria as biological agents to control Fusarium wilt disease and promote tomato plant growth. Physiol. Mol. Plant. Pathol. 2023, 125, 101994. [Google Scholar] [CrossRef]
- Hashem, A.; Akhter, A.; Alqarawi, A.A.; Singh, G.; Almutairi, K.F.; Abd-Allah, E.F. Mycorrhizal fungi induced activation of tomato defense system mitigates Fusarium wilt stress. Saudi J. Biol. Sci. 2021, 28, 5442–5450. [Google Scholar] [CrossRef] [PubMed]
- Zehra, A.; Aamir, M.; Dubey, M.K.; Ansari, W.A.; Meena, M.; Swapnil, P.; Upadhyay, R.S.; Ali, M.A.; Al-Ghamdi, A.A.; Lee, J. Enhanced protection of tomato against Fusarium wilt through biopriming with Trichoderma harzianum. J. King Saud. Unit. Sci. 2023, 35, 102466. [Google Scholar] [CrossRef]
- Sabuquillo, P.; Cal, A.D.; Melgarejo, P. Development of a dried Penicillium oxalicum conidial formulation for use as a biological agent against Fusarium wilt of tomato: Selection of optimal additives and storage conditions for maintaining conidial viability. J. King Saud. Unit. Sci. 2010, 54, 221–229. [Google Scholar] [CrossRef]
- Gonçalves, D.C.; Queiroz, V.T.; Costa, A.V. Reduction of Fusarium wilt symptoms in tomato seedlings following seed treatment with Origanum vulgare L. essential oil and carvacrol. Crop Prot. 2021, 141, 105487. [Google Scholar] [CrossRef]
- Ben-Jabeur, M.; Ghabri, E.; Myriam, M.; Hamada, W. Thyme essential oil as a defense inducer of tomato against gray mold and Fusarium wilt. Plant Physiol. Biochem. 2015, 94, 35–40. [Google Scholar] [CrossRef]
- Colson, E.; Savarino, P.; Claereboudt, E.J.S.; Cabrera-Barjas, G.; Deleu, M.; Lins, L. Enhancing the membranolytic activity of Chenopodium quinoa saponins by fast microwave hydrolysis. Molecules 2020, 25, 1731. [Google Scholar] [CrossRef]
- Yameng, H.; Jianwei, C.; Mingwei, Z.; Ruifen, Z.; Sanhong, F.; Lihong, D.; Fei, H.; Lei, L. Changes in saponins, phenolics and antioxidant activity of quinoa (Chenopodium quinoa Willd.) during milling process. LWT-Food Sci. Technol. 2019, 114, 108381. [Google Scholar]
- Hemalatha, P.; Bomzan, D.P.; Rao, B.V.S.; Sreerama, Y.N. Distribution of phenolic antioxidants in whole and milled fractions of quinoa and their inhibitory effects on α-amylase and α-glucosidase activities. Food Chem. 2016, 199, 330–338. [Google Scholar] [CrossRef] [PubMed]
- Rafik, S.; Rahmani, M.; Rodriguez, J.P.; Andam, S.; Ezzariai, A.; Gharous, M.E.; Karboune, S.; Choukr-Allah, R.; Hirich, A. How does mechanical pearling affect quinoa nutrients and saponin contents? Plants 2021, 10, 1133. [Google Scholar] [CrossRef] [PubMed]
- Ruiza, K.B.; Khakimov, B.; Engelsen, S.B.; Bak, S.; Biondi, S.; Jacobsen, S.E. Quinoa seed coats as an expanding and sustainable source of bioactive compounds: An investigation of genotypic diversity in saponin profiles. Ind. Crop Prod. 2017, 104, 156–163. [Google Scholar] [CrossRef]
- Woldemichael, G.M.; Wink, M. Identification and biological activities of triterpenoid saponins from Chenopodium quinoa. J. Agric. Food Chem. 2001, 49, 2327–2332. [Google Scholar] [CrossRef] [PubMed]
- Stuardo, M.; Martín, R.S. Antifungal properties of quinoa (Chenopodium quinoa Willd.) alkali treated saponins against Botrytis cinerea. Ind. Crop. Prod. 2008, 27, 296–302. [Google Scholar] [CrossRef]
- Dong, S.; Yang, X.; Zhao, L.; Zhang, F.; Hou, Z.; Xue, P. Antibacterial activity and mechanism of action saponins from Chenopodium quinoa Willd. husks against foodborne pathogenic bacteria. Ind. Crop. Prod. 2020, 149, 112350. [Google Scholar] [CrossRef]
- Medina-Meza, I.G.; Aluwi, N.A.; Saunders, S.R.; Ganjyal, G.M. GC-MS Profiling of triterpenoid saponins from 28 quinoa varieties (Chenopodium quinoa Willd.) grown in washington state. J. Agric. Food Chem. 2016, 64, 8583–8591. [Google Scholar] [CrossRef]
- Zhou, X.; Yue, T.; Wei, Z.; Yang, L.; Zhang, L.; Wu, B. Evaluation of nutritional value, bioactivity and mineral content of quinoa bran in China and its potential use in the food industry. Curr. Res. Food Sci. 2023, 7, 100562. [Google Scholar] [CrossRef]
- Hirose, Y.; Fujita, T.; Ishii, T.; Ueno, N. Antioxidative properties and flavonoid composition of Chenopodium quinoa seeds cultivated in Japan. Food Chem. 2010, 119, 1300–1306. [Google Scholar] [CrossRef]
- Sharma, S.; Kataria, A.; Singh, B. Effect of thermal processing on the bioactive compounds, antioxidative, antinutritional and functional characteristics of quinoa (Chenopodium quinoa). LWT-Food Sci. Technol. 2022, 160, 113256. [Google Scholar] [CrossRef]
- Mostafa, Y.S.; Alamri, S.A.; Alrumman, S.A.; Hashem, M.; Taher, M.A.; Baka, Z.A. In vitro and in vivo biocontrol of tomato Fusarium wilt by extracts from brown, red, and green macroalgae. Agriculture 2022, 12, 345. [Google Scholar] [CrossRef]
- Xue, P.; Zhao, L.; Wang, Y.; Hou, Z.; Zhang, F.; Yang, X. Reducing the damage of quinoa saponins on human gastric mucosal cells by a heating process. Food Sci. Nutr. 2020, 8, 500–510. [Google Scholar] [CrossRef] [PubMed]
- Nefzi, A.; Abdallah, R.A.B.; Jabnoun-Khiareddine, H.; Ammar, N.; Medimagh-Saïdana, S.; Haouala, R.; Daami-Remadi, M. Management of Fusarium Crown and Root Rot of tomato by Solanum linnaeanum L. extracts. Sci. Hortic. 2018, 238, 204–214. [Google Scholar] [CrossRef]
- Hajji-Hedfi, L.; Larayedh, A.; Hammas, N.-C.; Regaieg, H.; Horrigue-Raouani, N. Biological activities and chemical composition of Pistacia lentiscus in controlling Fusarium wilt and root-knot nematode disease complex on tomato. Eur. J. Plant Pathol. 2019, 155, 281–291. [Google Scholar] [CrossRef]
- Rongai, D.; Pulcini, P.; Pesce, B.; Milano, F. Antifungal activity of pomegranate peel extract against Fusarium wilt of tomato. Eur. J. Plant Pathol. 2017, 147, 229–238. [Google Scholar] [CrossRef]
- Hanaa, R.M.F.; Abdou, Z.A.; Salama, D.A.; Ibrahim, M.A.R.; Sror, H.A.M. Effect of neem and willow aqueous extracts on Fusarium wilt disease in tomato seedlings: Induction of antioxidant defensive enzymes. Ann. Agric. Sci-Cairo. 2011, 56, 1–7. [Google Scholar] [CrossRef]
- Chohan, S.; Perveen, R. Phytochemical analysis and antifungal efficacy of rhizome extracts of various plants against Fusarium wilt and root rot of tomato. Int. J. Agric. Biol. 2015, 17, 1193–1199. [Google Scholar] [CrossRef]
- Hlokwe, M.T.P.; Kena, M.A.; Mamphiswana, N.D. Evaluating crude extracts of Monsonia burkeana and Moringa oleifera against Fusarium wilt of tomato. Acta Agric. Scand. Sect. B—Soil Plant Sci. 2018, 68, 757–764. [Google Scholar] [CrossRef]
- Jasso de Rodríguez, D.; Gaytán-Sánchez, N.A.; Rodríguez-García, R.; Hernández-Castillo, F.D.; Díaz-Jiménez, L.; Villarreal-Quintanilla, J.A.; Flores-López, M.L.; Carrillo-Lomelí, D.A.; Peña-Ramos, F.M. Antifungal activity of Juglans spp. and Carya sp. ethanol extracts against Fusarium oxysporum on tomato under greenhouse conditions. Ind. Crop. Prod. 2019, 138, 111442. [Google Scholar] [CrossRef]
- Ramírez, P.G.; Ramírez, D.G.; Mejía, E.Z.; Ocampo, S.A.; Díaz, C.N.; Martínez, R.I.R. Extracts of Stevia rebaudiana against Fusarium oxysporum associated with tomato cultivation. Sci. Hortic. 2020, 259, 108683. [Google Scholar] [CrossRef]
- Arasu, M.V.; Al-Dhabi, N.A.; Choi, K.C.; Bensy, A.D.V.; Rajaselvam, J. Bioactive potential of Albizia lebbeck extract against phytopathogens and protective properties on tomato plant against speck disease in greenhouse. Physiol. Mol. Plant. Pathol. 2022, 117, 101750. [Google Scholar] [CrossRef]
- Singha, I.M.; Kakoty, Y.; Unni, B.G.; Kalita, M.C.; Das, J.; Naglot, A.; Wann, S.B.; Singh, L. Control of Fusarium wilt of tomato caused by Fusarium oxysporum f. sp. lycopersici using leaf extract of Piper betle L.: A preliminary study. World J. Microb. Biotechnol. 2011, 27, 2583–2589. [Google Scholar] [CrossRef]
- Smaili, A.; Mazoir, N.; Rifai, L.A.; Koussa, T.; Makroum, K.; Kabil, E.M.; Benharref, A.; Faize, M. Triterpene derivatives from Euphorbia enhance resistance against Verticillium wilt of tomato. Phytochemistry 2017, 135, 169–180. [Google Scholar] [CrossRef] [PubMed]
- Pérez, A.J.; Simonet, A.M.; Pecio, Ł.; Kowalczyk, M.; Calle, J.M.; Macías, F.A.; Oleszek, W.; Stochmal, A. Triterpenoid saponins from the aerial parts of Trifolium argutum Sol. and their phytotoxic evaluation. Phytochem. Lett. 2015, 13, 165–170. [Google Scholar] [CrossRef]
- Liu, W.; Wu, L.; Wu, H.; Zheng, S.; Wang, J.; Liu, F. Correlation of saponin content and Fusarium resistance in hybrids from different ploidy levels of Lilium Oriental. Sci. Hortic. 2011, 129, 849–853. [Google Scholar] [CrossRef]
- Radwan, A.M.; Alghamdi, H.A.; Sahar, K.M. Kenawy Effect of Calotropis procera L. plant extract on seeds germination and the growth of microorganisms. Ann. Agric. Sci. 2019, 64, 183–187. [Google Scholar] [CrossRef]
- Ucella-Filho, J.G.M.; Freire, A.D.S.M.; Carrera, J.C.; Lucas, F.M.F.; Zucolotto, S.M.; Junior, A.F.D.; Mori, F.A. Tannin-rich bark extract of plants as a source of antimicrobial bioactive compounds: A bibliometric analysis. S. Afr. J. Bot. 2022, 150, 1038–1050. [Google Scholar] [CrossRef]
| Saponin (%) | Protein (%) | Fat (%) | Polyphenols (%) | Flavonoids (%) | Tannins (%) | Moisture (%) | Ash (%) |
|---|---|---|---|---|---|---|---|
| 66.1 ± 0.4 | 5.97 ± 0.15 | 0.45 ± 0.11 | 0.25 ± 0.01 | 0.61 ± 0.10 | 0.57 ± 0.21 | 5.77 ± 0.04 | 9.5 ± 1.0 |
| Treatment Agent | Concentration (g/L) | Seedling Emergence Rate (%) | |
|---|---|---|---|
| 7th Day after Sowing | 10th Day after Sowing | ||
| Quinoa saponins | 0.5 | 32 b | 76 b |
| Quinoa saponins | 1.0 | 40 b | 72 b |
| Thiram carboxin | 1.0 | 12 c | 76 b |
| Control | 0 | 84 a | 96 a |
| Treatment Agent | Concentration (g/L) | Mycelial Inhibition Rate (%) |
|---|---|---|
| Quinoa saponins | 0.5 | 4.76 ± 0.91 |
| Quinoa saponins | 1.0 | 9.52 ± 1.29 |
| Treatment Agent | Concentration (g/L) | Disease Incidence (%) | Preventive Effects (%) |
|---|---|---|---|
| Quinoa saponins | 0.5 | 32.59 ± 0.71 b | 49.26 ± 1.10 c |
| Quinoa saponins | 1.0 | 30.58 ± 0.78 bc | 52.39 ± 1.21 b |
| Thiram carboxin | 1.0 | 27.20 ± 0.71 c | 57.66 ± 1.10 a |
| Control | 0 | 64.23 ± 2.61 a | — |
| Treatment Agent | Concentration (g/L) | Disease Incidence (%) | Preventive Effects (%) |
|---|---|---|---|
| Quinoa saponins | 0.5 | 20.61 ± 0.65 b | 57.12 ± 1.36 c |
| Quinoa saponins | 1.0 | 18.24 ± 0.51 bc | 62.04 ± 1.06 b |
| Thiram carboxin | 1.0 | 16.60 ± 0.30 c | 65.45 ± 0.63 a |
| Control | 0 | 48.06 ± 1.83 a | — |
| Treatment Agent | Concentration (g/L) | Disease Incidence (%) | Preventive Effects (%) |
|---|---|---|---|
| Quinoa saponins | 0.5 | 23.39 ± 0.55 b | 53.54 ± 1.08 c |
| Quinoa saponins | 1.0 | 22.19 ± 0.27 c | 55.92 ± 0.54 b |
| Thiram carboxin | 1.0 | 15.91 ± 0.03 d | 68.40 ± 0.06 a |
| Control | 0 | 50.35 ± 0.48 a | — |
Disclaimer/Publisher’s Note: The statements, opinions and data contained in all publications are solely those of the individual author(s) and contributor(s) and not of MDPI and/or the editor(s). MDPI and/or the editor(s) disclaim responsibility for any injury to people or property resulting from any ideas, methods, instructions or products referred to in the content. |
© 2023 by the authors. Licensee MDPI, Basel, Switzerland. This article is an open access article distributed under the terms and conditions of the Creative Commons Attribution (CC BY) license (https://creativecommons.org/licenses/by/4.0/).
Share and Cite
Zhou, X.; Guo, H.; Zhang, L.; Yang, L.; Wei, Z.; Zhang, X.; Niu, Y. Crude Saponins from Chenopodium quinoa Willd. Reduce Fusarium Wilt Infection in Tomato Seedlings. Horticulturae 2023, 9, 1340. https://doi.org/10.3390/horticulturae9121340
Zhou X, Guo H, Zhang L, Yang L, Wei Z, Zhang X, Niu Y. Crude Saponins from Chenopodium quinoa Willd. Reduce Fusarium Wilt Infection in Tomato Seedlings. Horticulturae. 2023; 9(12):1340. https://doi.org/10.3390/horticulturae9121340
Chicago/Turabian StyleZhou, Xueyong, Huan Guo, Lihong Zhang, Liyan Yang, Zuofu Wei, Xiaoying Zhang, and Yan Niu. 2023. "Crude Saponins from Chenopodium quinoa Willd. Reduce Fusarium Wilt Infection in Tomato Seedlings" Horticulturae 9, no. 12: 1340. https://doi.org/10.3390/horticulturae9121340
APA StyleZhou, X., Guo, H., Zhang, L., Yang, L., Wei, Z., Zhang, X., & Niu, Y. (2023). Crude Saponins from Chenopodium quinoa Willd. Reduce Fusarium Wilt Infection in Tomato Seedlings. Horticulturae, 9(12), 1340. https://doi.org/10.3390/horticulturae9121340

